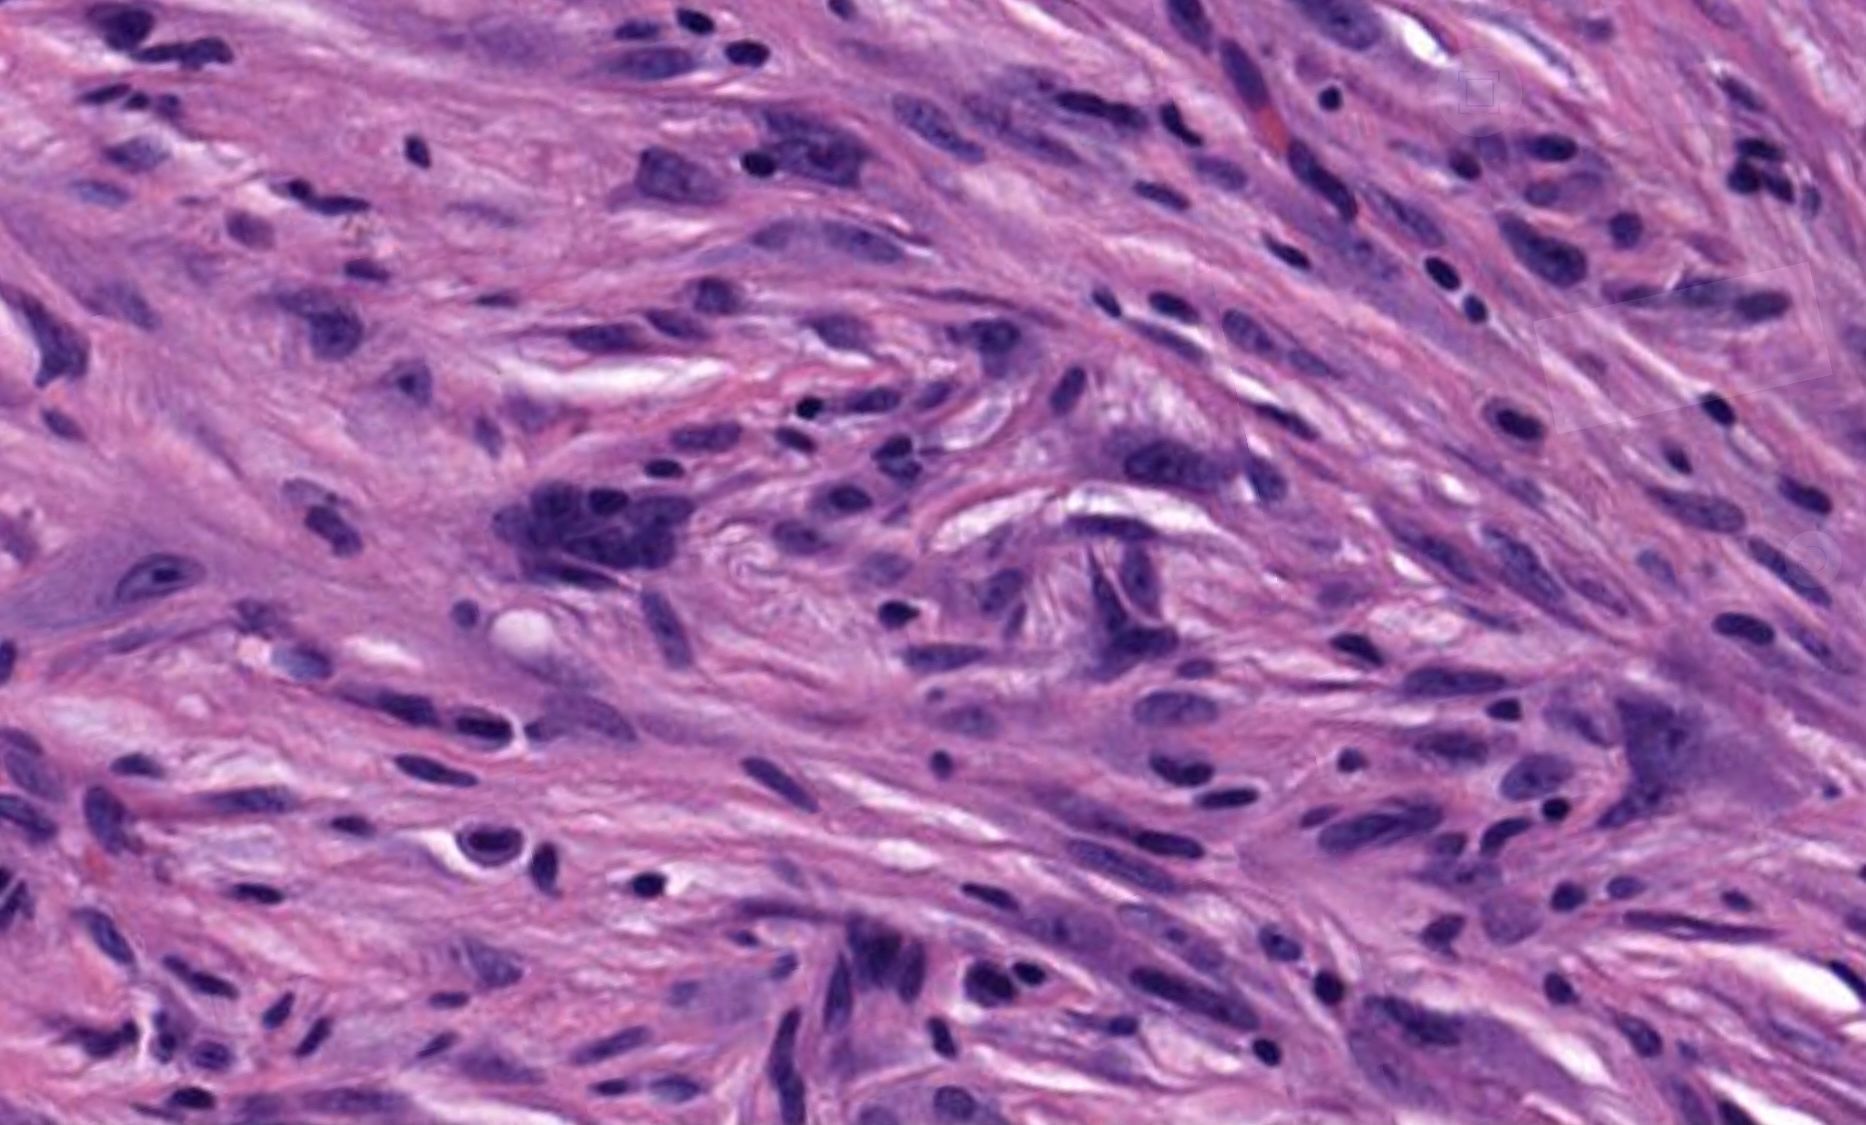
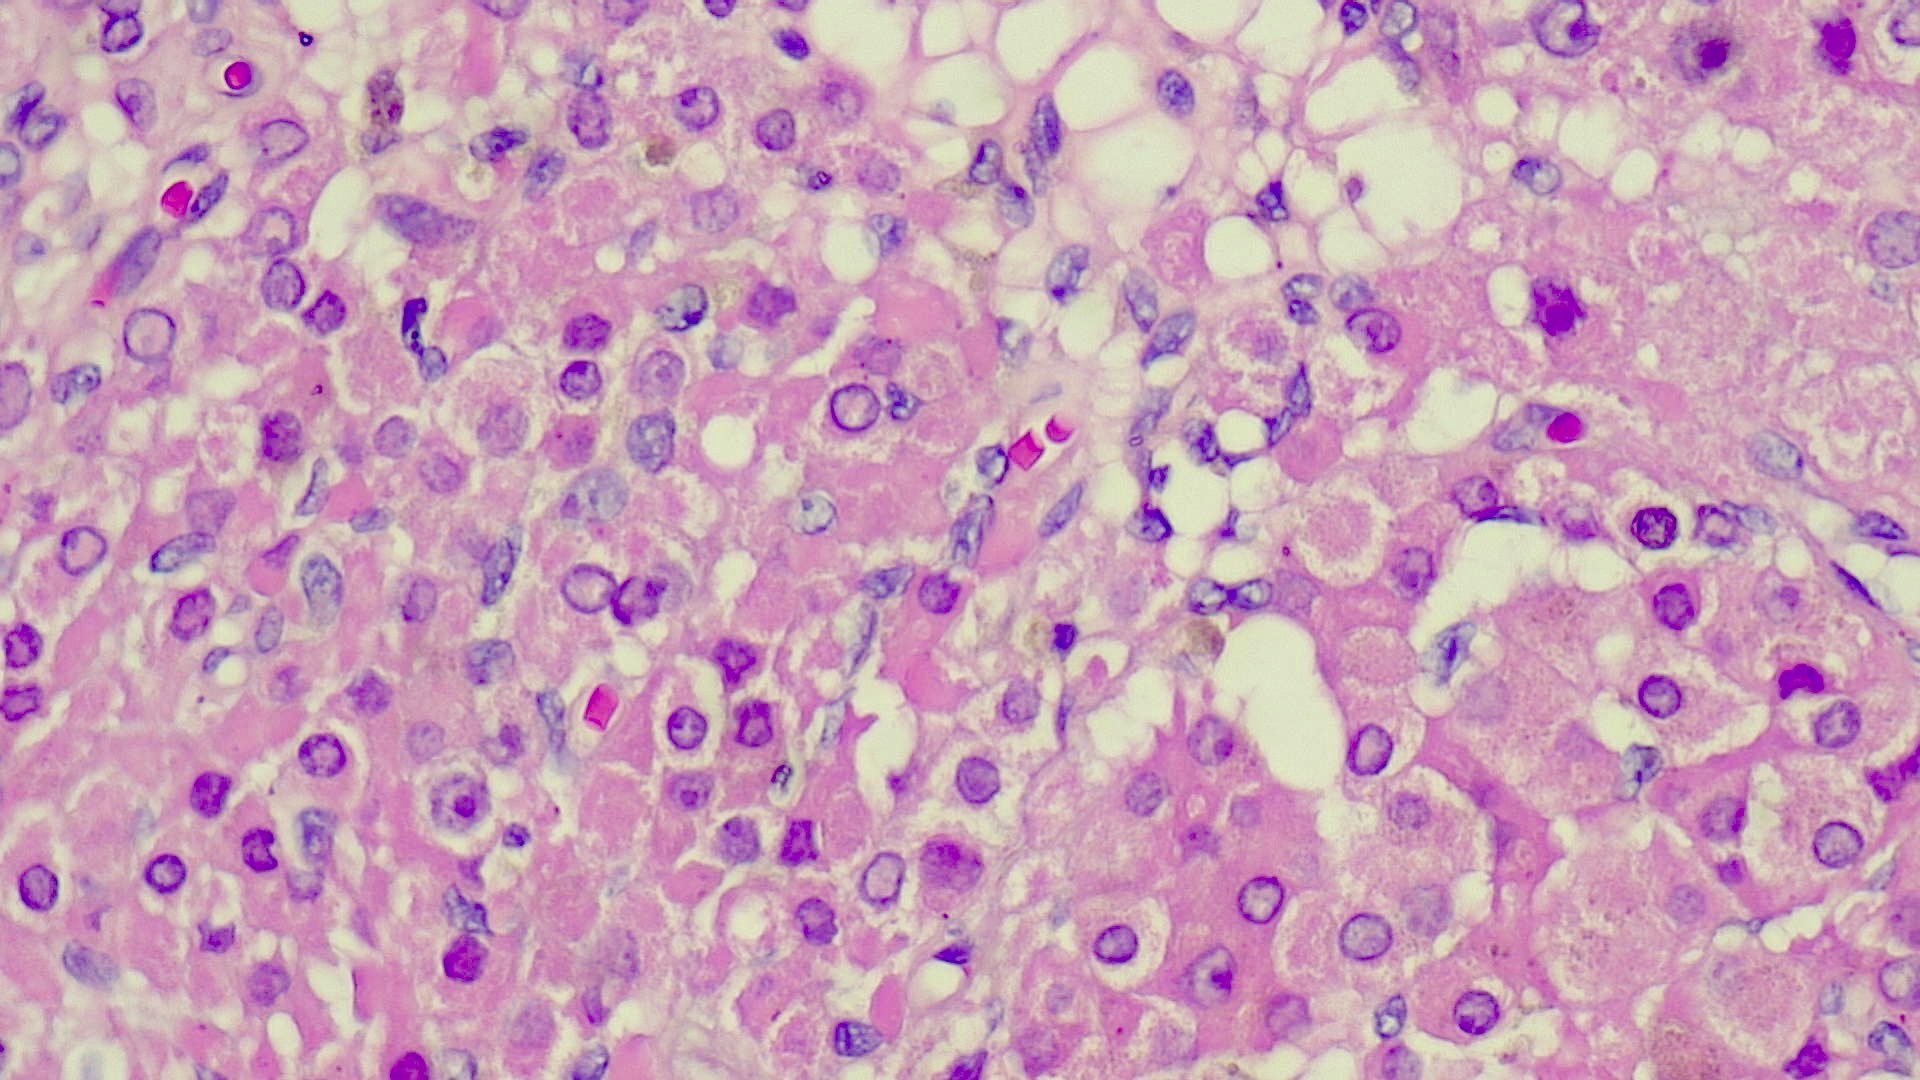
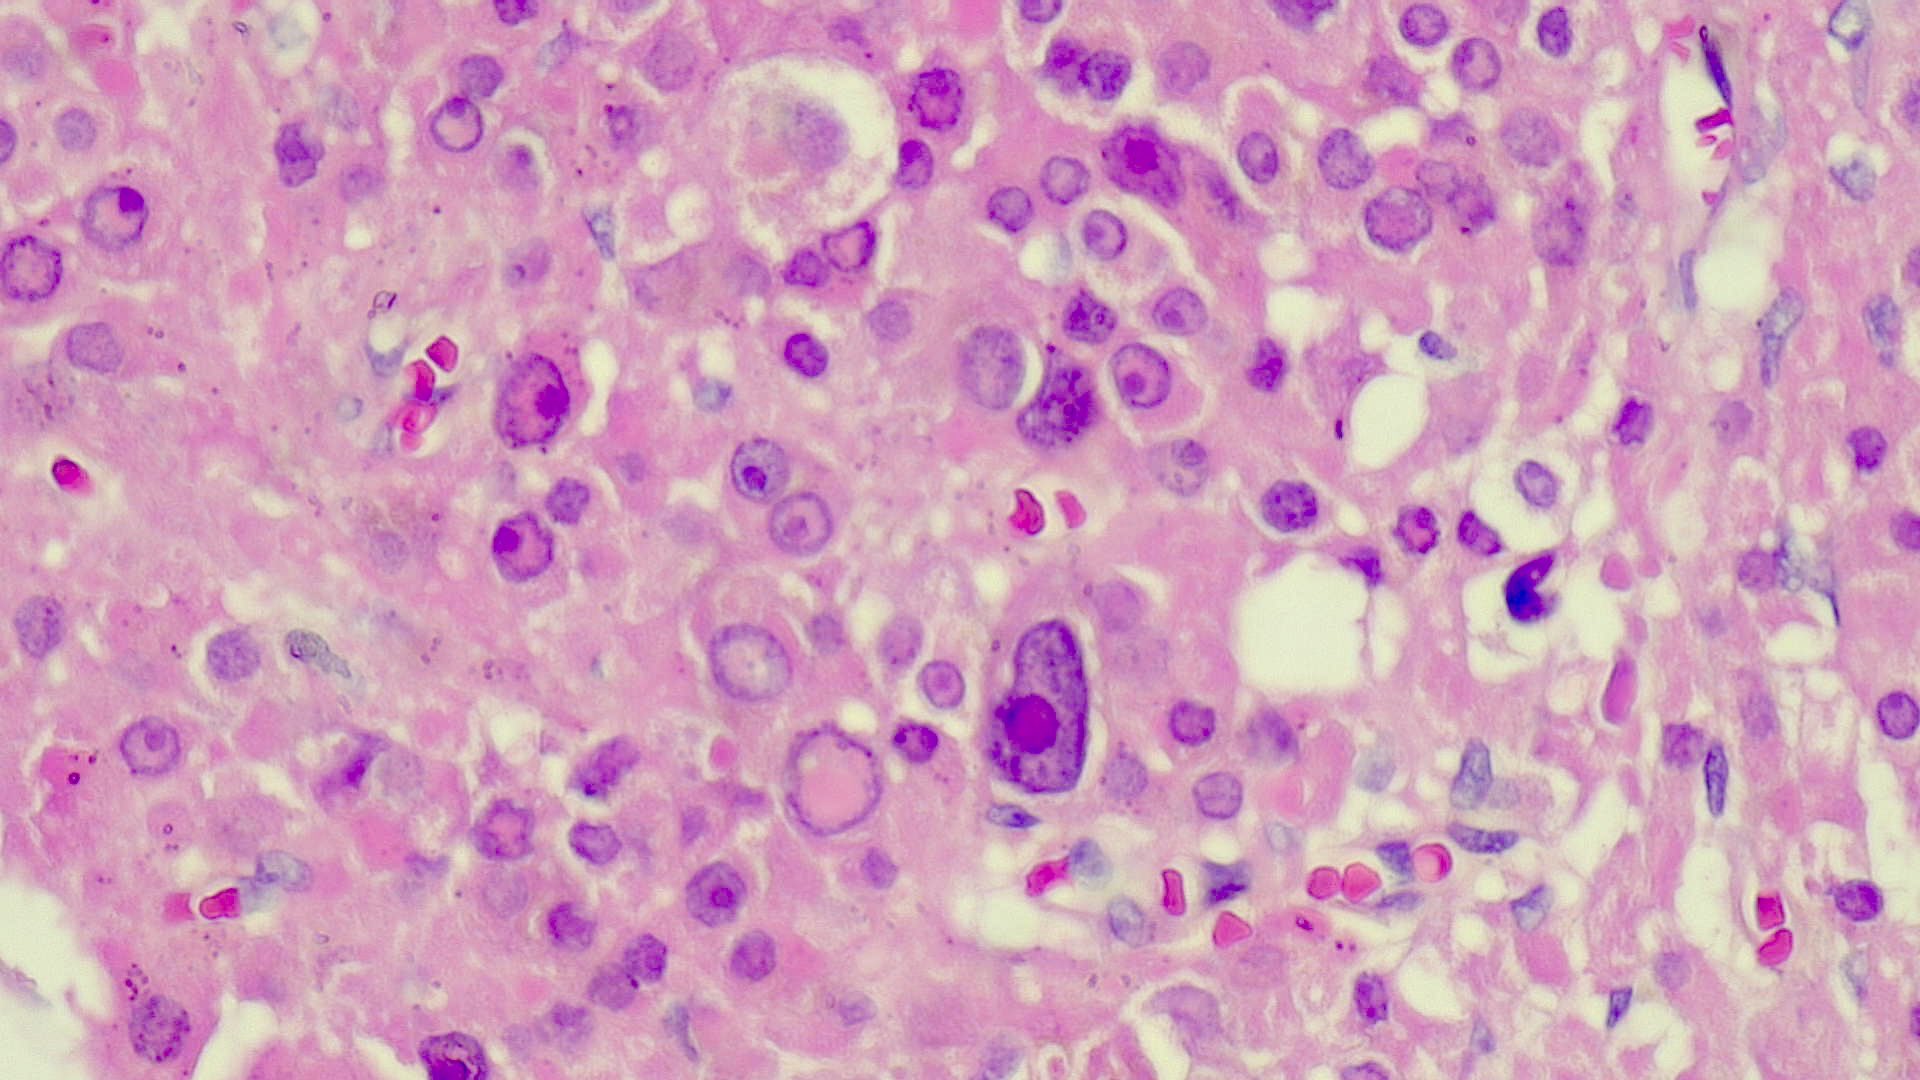

Vulvar skin biopsy. Erythematous pruritic eruption. Your diagnosis?
Answer ✅ youtu.be/r_jYeBjCeXk
Only H&E stain needed for this one!
#pathology #pathologists #pathTwitter #dermpath #dermatology #dermatologia #dermtwitter #gynpath #obgyntwitter

5